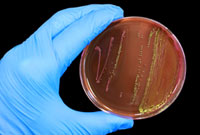

Chargement...
Théologie biblique de la maladie
Avec Romains 8, Henri Blocher fait une synthèse des données bibliques sur la maladie. Il n'est pas question de souffrance ou de guérison, mais du voca...
1976•Blocher Henri
72:28

1976
Avec Romains 8, Henri Blocher fait une synthèse des données bibliques sur la maladie. Il n'est pas question de souffrance ou de guérison, mais du vocabulaire biblique de la maladie, de son origine et des sens qu'on peut lui donner.
Mots-clés
Mots-clés
Enregistrements connexes
Sur le même thème
Playlists
Dernières playlists mises à jour

18 enreg.
Livre audio - Au fil de la foi : grandir avec Dieu, une lettre à la fois
+8

16 enreg.
CD - ResKP
+6

30 enreg.
On n'a rien à cacher - Partie 2
+20

21 enreg.
Bible en main
+11

4 enreg.
On n'a rien à cacher - Partie 3

14 enreg.
Ascension de Jésus
+4

34 enreg.
L'éducation des enfants
+24

16 enreg.
CD - Chemin vers le ciel
+6